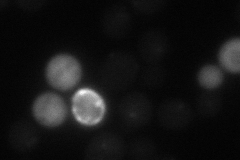
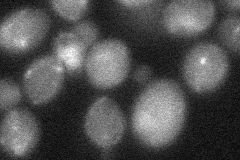
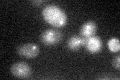

View description
Outer kinetochore protein, required for accurate mitotic chromosome segregation; component of the kinetochore sub-complex COMA (Ctf19p, Okp1p, Mcm21p, Ame1p) that functions as a platform for kinetochore assembly
Localization:
Intensity:
Fold change:
Significance:
-
C’ GFP library in SD

punctate22.53 -
N' NOP1pr-GFP in SD

punctate,vacuole membrane42.2343 -
N' TEF2pr-mCherry in SD
punctate14.3798 -
N' NATIVEpr-GFP in SD

punctate23.3828 -
N' TEF2pr-VC and Cyto-VN in SD
below threshold24.7785 -
C’ GFP library in SD+DTT

punctate17.040.75Yes -
C’ GFP library in SD+H2O2

punctate19.460.86No -
C’ GFP library in Starvation Media
punctate25.711.14No -
C’ GFP library on the background of Pup2-DaMP

punctate -
C’ GFP library on the background of CCT mutant

punctate23.89741.06013No
